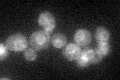
YBL011W
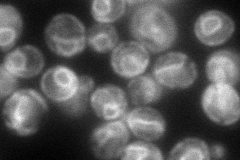
YBL011W
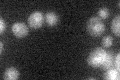
YBL011W

View description
Glycerol 3-phosphate/dihydroxyacetone phosphate dual substrate-specific sn-1 acyltransferase of the glycerolipid biosynthesis pathway, prefers 16-carbon fatty acids, similar to Gpt2p, gene is constitutively transcribed
Localization:
Intensity:
Fold change:
Significance:
-
C’ GFP library in SD
ER34.97 -
N' NOP1pr-GFP in SD

ER78.3859 -
N' TEF2pr-mCherry in SD
ER90.1998 -
N' NATIVEpr-GFP in SD

ambiguous,ER20.9899 -
N' TEF2pr-VC and Cyto-VN in SD

ER,punctate36.4732 -
C’ GFP library in SD+DTT

ER25.640.73No -
C’ GFP library in SD+H2O2

ER31.010.88No -
C’ GFP library in Starvation Media
ER27.930.79No -
C’ GFP library on the background of Pup2-DaMP

ER -
C’ GFP library on the background of CCT mutant

ER28.44940.813459No
